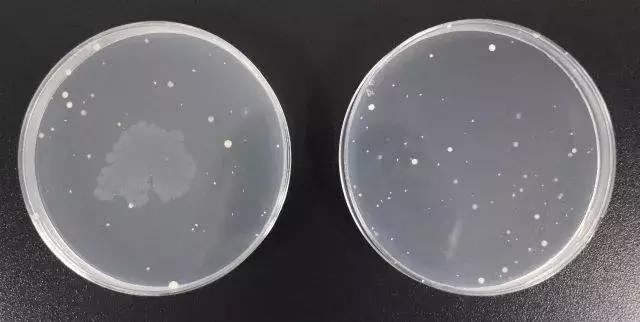
粉扑怎么消除细菌,清洗粉扑细菌
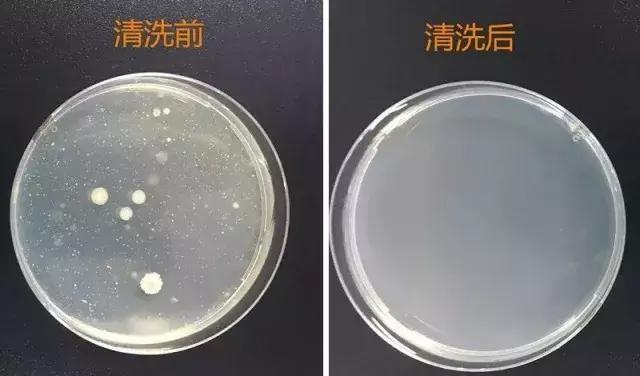
粉扑怎么消除细菌,清洗粉扑细菌

作为一个精致女孩,包包里怎么少的了口红、眼影、气垫bb霜咧?Ta们可是精致女孩走向女神的必备法宝!

可是姑娘们知道吗?由于底妆产品含油量较高(尤其是BB霜和粉饼)3天不清洗的粉扑,比马桶都要脏2倍!

专家证实,这些化妆工具七天不洗,一片粉扑可以滋生出8万个左右的细菌!简直各类细菌的繁殖“福地”。

所以用了千元的精华,百元的卸妆乳,一段时间后发现自己肌肤还是会出现各种问题:闭口粉刺!大毛孔!痘痘!而且妆容也开始不服帖浮粉、卡粉,就不用过于惊讶了!

粉扑一定要经常清洗!而且一定要用专门的清洗剂清洗!使用肥皂或其他清洗剂会使粉扑变形损坏!

说到这个粉扑清洗剂,相信很多小仙女都听过这款白菜神物——Daiso大创粉扑清洗剂

无着色、无添加、无香料,杀菌除臭、清洁不伤肤,只要几滴就可以彻底清洁粉扑上的积粉。90%回购率的日本国民必备粉扑清洗剂!洗完后的粉扑、散粉刷 洁净完好如新,而且完蓬松柔软!

来自日本百元老店
看到Daiso大创这个牌子,小编脑中立马就浮现了“平价大牌”、 “大白菜的价格轻奢品的性能”、 “日本的国民品牌”这几个词,不过也确实,热门产品更是一大堆,东西好用到需要抢。

成立于1972年的Daiso在日本真的是家喻户晓,4000多个连锁店让你每走一站都能看到它的身影,是日本百元店的元老。

Daiso粉扑清洗剂不止是日本的网红,在国内也是深受仙女的喜爱,小红书近5000的讨论帖!

三无添加杀菌不伤肤
粉扑这种东西,每天都在和肌肤接触,它的清洗剂成分一定要够安全,这点Daiso完全满足妹纸们的选购要求!

无着色、无添加、无香料主要成分是:天然植物油、乳化剂、界面活性剂其余之后再无任何添加剂!



这些成分在许多化妆品中都是常见成分,安全无刺激,所以妹纸们放心~

清洗效果 洁净如新
这瓶小小的清洗剂看起来不是很起眼,洗起粉扑刷子,绝不手下留情!清洗效果杠杠的!

首先看粉扑
清洗前有木有感觉,每次使用粉扑都有无数细菌在脸上愉快跳舞!

将要清洗的粉扑打湿,挤上几滴清洗液,轻轻揉搓,积粉就乖乖都出来了!

清洗后有木有想刚拆封的新粉扑!

即使是海绵粉扑,也能干净如新还不变形!!

彩妆蛋
就算是比较厚重的彩妆蛋,也能轻松洗净!

化妆刷
厚厚的糊着一层残余粉和角质皮屑!只需两三滴再轻轻搅拌冲洗之后,哒哒变新刷!

清洗化妆刷,可以在容器里挤上清洗剂,先把刷子泡一泡,再顺一个方向轻轻转动,这样可以把刷子缝隙中藏积的粉清洗干净~

最后用纸巾吸干多余水分,阴凉处晾干就又变新刷子喽~

清洗效果是达到了,除菌效果怎么样一起来看下!
除菌效果zei好
这是显微镜未清洗的粉扑内隐藏的细菌!

为了方便直接观察,工程师把样品稀释液和固体培养基混匀,通过培养箱培养后才能看到一个个肉眼可见的细菌菌落。

星星点点的都是细菌菌落!清水清洗后的菌落依旧存在……
再来看Daiso粉扑清洗剂清洗后的细菌菌落残留状况!细菌残留为零!
清洗小诀窍
实在不想沾手的妹纸,还可以找个保鲜袋,放上水挤上清洗剂,然后轻轻挤压同样能起到清洗效果哟~

ta很划算
对于有些妹纸来说,又是花上千元买祛痘产品,又是喝中药治痘,又是每周抽空去粉刺。

买上一瓶Daiso粉扑清洗剂, 从根源上杜绝痘痘和粉刺出现的机会,而不过百的ta在治痘显然要划算很多!
为了防止运输途中出现撒漏现象,80ml的Daiso粉扑清洗剂装在了100ml的瓶子里, 所以收到清洗液只有大半瓶,不是小编偷倒的,也并非运输途中洒漏了,而是产品本身的设计问题哟~

清洗剂没有味道,透明的质地更像是家里用的洗洁精,泡沫细腻不会很多。

非常容易清洗干净,也不会有残留,妹纸尽可放心用!用过的妹纸也都chao爱ta!

用过都说好
用过的妹纸对Daiso粉扑清洗剂赞不绝口!




最后小提示
清洗过的用干毛巾或者纸巾将粉扑中的水分按压干,注意千万不要拧干或者暴晒, 否则粉扑很容易折断或裂开。放在阴凉通风的地方自然晾干就好。
